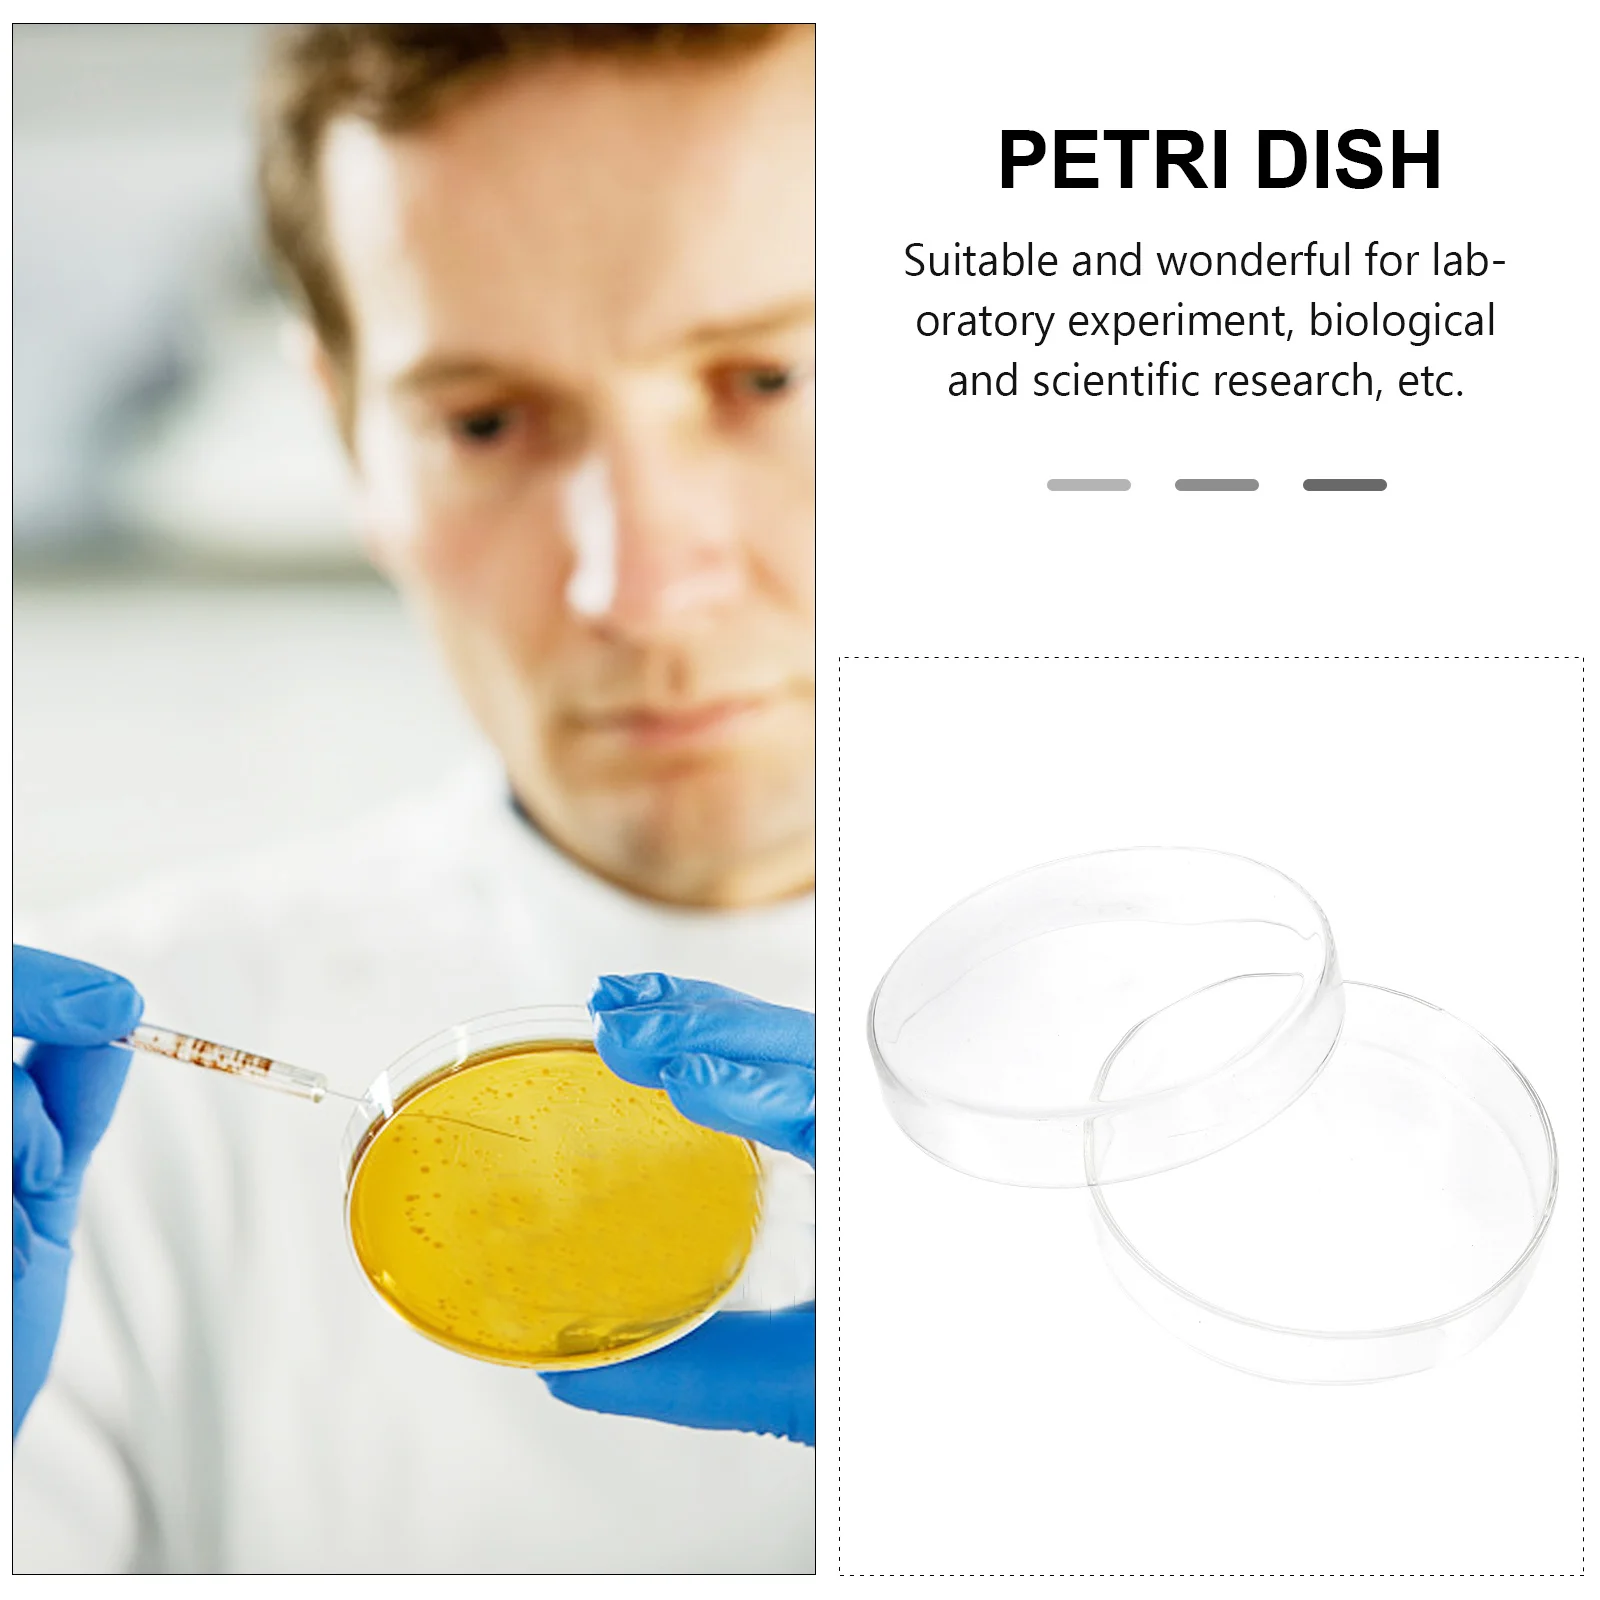
1 шт., лабораторная чашка Петри, прозрачное стекло, дизайн, инструмент для клеточной культуры для биологических и научных экспериментов, стеклянные чашки Петри

Женское быстросохнущее банное полотенце с милым бантом, спа-салфетки и шапочка для душа, набор халатов синий
Price history chart & currency exchange rate
Customers also viewed

4,308.88 руб.
Это ссылка для оплаты доставки или оплаты после получения посылки, спасибо за сотрудничество
aliexpress.ru
6,702.70 руб.
Для ChangAn Auchan X5 2021 Penutup Lampu Depan Butik Transparan Lampshdade Lampu Kepala Cangkang оргстекло Ganti Lensa Asli
aliexpress.ru
2,687.46 руб.
Органайзер для сумок, купить Сумка для овощей, потяните корзину на колесах, шоппинг, портативные большие женские сумки, складная тележка, рынок
aliexpress.ru
817.09 руб.
Подходит для робота-пылесоса Narwal J1J2, Сменные аксессуары, фильтр экрана, края, щетка, чистящая ткань
aliexpress.ru
1,393.20 руб.
Брюки женские с завышенной талией, модные однотонные свободные прямые повседневные штаны с широкими штанинами, на шнуровке, весна-осень 2022
aliexpress.ru
3,246.82 руб.
GAO студийные магнитные кешью гайки Push слайдер декомпрессионные игрушки офисные магнитные игрушки
aliexpress.ru
1,129.88 руб.
Корейские мужские брюки для гольфа, весна-осень, Высококачественная эластичная одежда для гольфа, спортивные брюки, Длинные деловые повсед...
aliexpress.ru
928.80 руб.
Женское платье, элегантное весеннее платье 2023, женские длинные однотонные платья с рукавами-фонариками, офисное женское платье с высокой талией
aliexpress.ru
880.13 руб.
V ременной шкив отверстие с двойным пазом для двигателей ATV Go Kart 168F 170F GX110 GX120 GX160 GX200 7HP
aliexpress.ru
879.33 руб.
Акриловый прозрачный чехол с поворотом на 360 ° для Xiaomi Pad 6, 2023, 11 дюймов, для Xiaomi Pad 6 Pro, для MiPad 5, 5 Pro, 11 дюймов, подставка
aliexpress.ru
763.63 руб.
Автомобильные аксессуары, новый датчик давления воздуха 17109AM 021-1041 Q21-1041 5005758, подходит для VOLVO
aliexpress.ru
679.05 руб.
Биты для отверток t40 с шестигранной головкой, магнитные биты Torx 2/4/5, 25 мм, сплав S2, набор инструментов для электрической отвертки
aliexpress.ru
284.86 руб.
Романтический рюкзак с акварелью, цветочным букетиком, портативные сумки на шнурке, сумка с карманами на шнурке для путешествий, студентов
aliexpress.ru
2,223.06 руб.
Складная деревянная горелка из нержавеющей стали, складная горелка для охоты, рыбалки, пикника, кемпинга
aliexpress.ru
265.71 руб.
Сверло зенковочное из быстрорежущей стали с 3 канавками, 90 градусов, 2 шт., 44-64 мм
aliexpress.ru
209.86 руб.
Топ сексуальный бесшовный и удобный бюстгальтер, мягкий и плотно прилегающий, женские бюстгальтеры пуш-ап, женское плотное нижнее белье
aliexpress.ru
382.21 руб.
Аниме история богини Новинка 5M07 Xr Zr Mr Ins Ssr Sr R Ningguang Yae Sakura цельный кусок Коллекционная коробка карточная игрушка детский подарок на день рожд...
aliexpress.ru
237.79 руб.
Женские шорты для активного отдыха с карманами, женские летние свободные брюки-Капри с широкими штанинами и завязками на талии, женское кор...
aliexpress.ru
785.17 руб.
Зимняя шапка, кепка с ушками для женщин, бейсболка с бархатной подкладкой для активного отдыха, ретро клетчатые Женские аксессуары, шерстяная женская шляпа HatBQM211
aliexpress.ru
1,860.00 руб.
10,1 дюймовый автомобильный радиоприемник установка Android рамка Fascia подходит для MAZDA CX-9 2009 стерео GPS DVD плеер Установочная панель
aliexpress.ru
598.46 руб.
Боковая подставка с ЧПУ для мотоцикла, увеличивающая пластину, подставка для ног для BMW F800GT G800GT 2013-2015 2014 F 800 GT F800 GT F 800GT
aliexpress.ru